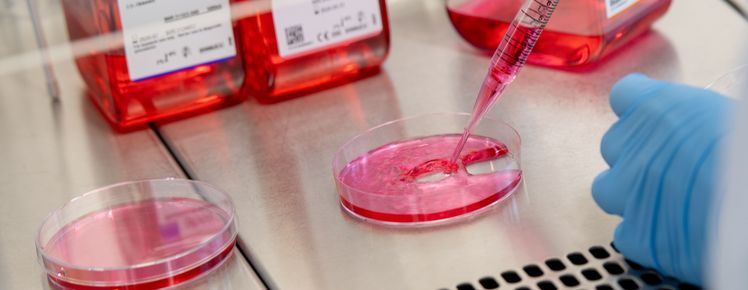

Kontakt
Direktorin
Postanschrift
Immunologie
Die Immunologie befasst sich mit den Abwehrmechanismen des Körpers gegen Krankheitserreger wie Bakterien, Viren, Pilze und Parasiten sowie gegen andere körperfremde Stoffe (zum Beispiel Toxine oder Umweltgifte). Das Immunsystem setzt sich aus einer Vielzahl von zellulären und molekularen Prozessen zusammen, die für die Erkennung und Inaktivierung von Krankheitserregern oder körperfremden, „schädlichen“ Einflüssen verantwortlich sind. Durch die zentrale Rolle im menschlichen Körper sind Fehlfunktionen der körpereigenen Abwehr an der Entstehung und dem Verlauf von ganz unterschiedlichen Erkrankungen beteiligt, wie beispielsweise Entzündungen und Infektionen, Allergien, Transplantatabstoßungen, Autoimmunkrankheiten oder Tumoren.
Weitere Informationen
Unsere Arbeitsgruppe untersucht zelluläre und molekulare Mechanismen, die der Entstehung komplexer Entzündungserkrankungen, der systemischen Autoimmunität oder der Toleranzinduktion zugrunde liegen. Darüber hinaus beschäftigen wir uns mit der Regulation von angeborenen und erworbenen Immunantworten bei Infektionen oder der Progression von Tumoren sowie mit der Interaktion des Immunsystems mit dem Nervensystem. Mit diesen Ansätzen beabsichtigen wir, Signalwege und Prozesse, die der Kontrolle von Zellaktivierung, Zellmigration oder Zell-Zell-Kommunikation zugrunde liegen, besser zu verstehen und auf diese Weise zur Aufklärung von Pathomechanismen (systemischer) immunvermittelter Erkrankungen beitragen oder Ideen für die Entwicklung innovativer therapeutischer Konzepte liefern zu können. Da die Regulation des Immunsystems nicht nur durch Organe, Gewebe oder Zellen des Organismus selbst bestimmt wird, sondern ebenfalls durch externe Faktoren (z.B. Umwelteinflüsse, Lebensstilfaktoren) gesteuert werden kann, beinhalten unsere Arbeiten auch Analysen zur Interaktion von Umwelt und Organismus. In diesem Zusammenhang interessieren wir uns insbesondere für Signalwege und Mechanismen, die die Übertragung von externen Stimuli in Immunantworten vermitteln. Des Weiteren befassen wir uns mit neurosensorischen Prozessen und der Sinneswahrnehmung im Auge sowie mit der Identifikation von Biomarkern (Genom- und Transkriptomanalysen, auch auf Einzelzellebene) oder der Charakterisierung von Veränderungen des Mikrobioms bei Entzündungserkrankungen.
Für die zielgerichtete Beantwortung unserer Fragestellungen setzen wir ganz unterschiedliche Methoden ein. Dazu gehören beispielsweise komplexe Zellkultursysteme oder innovative Tiermodelle, die wir zum großen Teil selbst entwickelt haben. Darüber hinaus kommen Standardmethoden der Immunologie, Histologie, Zell- und Molekularbiologie zum Einsatz.

Direktorin:
Lehre
- Immunologie für den Studiengang Humanmedizin
- Immunologie für den Studiengang Molekulare Biomedizin
Lehrveranstaltungen
Sommersemester 2025
6.04.121 Tumor Biology - Lecture
6.04.150.003 Novel immunomodulatory tripeptides for the in vitro treatment of human immune and endothelial cells
OLT.25.05.01 OLTECH Mid-term Workshop 22.05.2025
Weitere Informationen auch unter:
Forschung
Zu den Hauptforschungsgebieten der Abteilung für Immunologie gehören:
- Neuroimmunologie und Neuroimmun-Kommunikation
- Immun-Environment-Interaction
- Immunregulation, systemische Autoimmunität und Toleranzinduktion
- Steuerung der anti-mikrobiellen und anti-tumoralen Immunität in epithelialen Barrieregeweben
- Neurosensorische Prozesse und die Rolle des Immunsystems bei der Sinneswahrnehmung im Auge
Hier finden Sie eine Übersicht über die Publikationen

